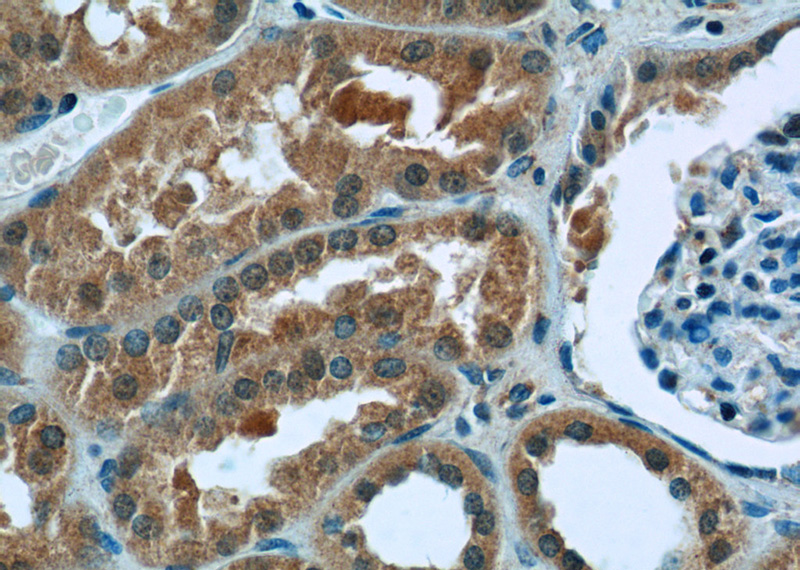
Immunohistochemistry of paraffin-embedded human kidney tissue slide using Catalog No:116929(ZC3HAV1 Antibody) at dilution of 1:50 (under 40x lens)

-
Product Name
ZC3HAV1 antibody
- Documents
-
Description
ZC3HAV1 Rabbit Polyclonal antibody. Positive IP detected in HeLa cells. Positive WB detected in HEK-293 cells, HeLa cells. Positive IHC detected in human testis tissue, human kidney tissue. Observed molecular weight by Western-blot: 100 kDa
-
Tested applications
ELISA, WB, IHC, IP
-
Species reactivity
Human,Mouse,Rat; other species not tested.
-
Alternative names
DKFZp686F2052 antibody; DKFZp686H1869 antibody; DKFZp686O19171 antibody; FLB6421 antibody; FLJ13288 antibody; ZAP antibody; ZC3H2 antibody; ZC3HAV1 antibody; ZC3HDC2 antibody; Zinc finger antiviral protein antibody
-
Isotype
Rabbit IgG
-
Preparation
This antibody was obtained by immunization of ZC3HAV1 recombinant protein (Accession Number: NM_024625). Purification method: Antigen affinity purified.
-
Clonality
Polyclonal
-
Formulation
PBS with 0.1% sodium azide and 50% glycerol pH 7.3.
-
Storage instructions
Store at -20℃. DO NOT ALIQUOT
-
Applications
Recommended Dilution:
WB: 1:1000-1:10000
IP: 1:1000-1:10000
IHC: 1:20-1:200
-
Validations

HEK-293 cells were subjected to SDS PAGE followed by western blot with Catalog No:116929(ZC3HAV1 Antibody) at dilution of 1:4000

IP Result of anti-ZC3HAV1 (IP:Catalog No:116929, 4ug; Detection:Catalog No:116929 1:2000) with HeLa cells lysate 1080ug.

Immunohistochemistry of paraffin-embedded human testis tissue slide using Catalog No:116929(ZC3HAV1 Antibody) at dilution of 1:50 (under 40x lens)
Immunohistochemistry of paraffin-embedded human kidney tissue slide using Catalog No:116929(ZC3HAV1 Antibody) at dilution of 1:50 (under 40x lens)
-
Background
The zinc-finger antiviral protein (ZAP) was originally identifed from a rat cDNA library due to its conferring resistance to retroviruses. ZC3HAV1 is a CCCH-type zinc finger protein, it may primarily function to inhibit viral gene expression and induce an innate immunity to viral infection. Alternative splicing occurs at this locus and two variants, each encoding distinct isoforms.
-
References
- Mao R, Nie H, Cai D. Inhibition of hepatitis B virus replication by the host zinc finger antiviral protein. PLoS pathogens. 9(7):e1003494. 2013.
- Moldovan JB, Moran JV. The Zinc-Finger Antiviral Protein ZAP Inhibits LINE and Alu Retrotransposition. PLoS genetics. 11(5):e1005121. 2015.
- Goodier JL, Pereira GC, Cheung LE, Rose RJ, Kazazian HH. The Broad-Spectrum Antiviral Protein ZAP Restricts Human Retrotransposition. PLoS genetics. 11(5):e1005252. 2015.
- Li M, Yan K, Wei L. Zinc finger antiviral protein inhibits coxsackievirus B3 virus replication and protects against viral myocarditis. Antiviral research. 123:50-61. 2015.
Related Products / Services
Please note: All products are "FOR RESEARCH USE ONLY AND ARE NOT INTENDED FOR DIAGNOSTIC OR THERAPEUTIC USE"
